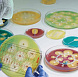

Мы приняли вашу заявку, свяжемся с вами в ближайшее время.

История
+7 (812) 372-60-40
Ваш регион Москва?
!
Возможно, вы сменили регион при заполнении корзины.
Часть товаров из корзины будет перемещена в статус отложенных и не сможет быть оформлена для заказа, если вы продолжите работу в данном регионе
Часть товаров из корзины будет перемещена в статус отложенных и не сможет быть оформлена для заказа, если вы продолжите работу в данном регионе
Отменить
История